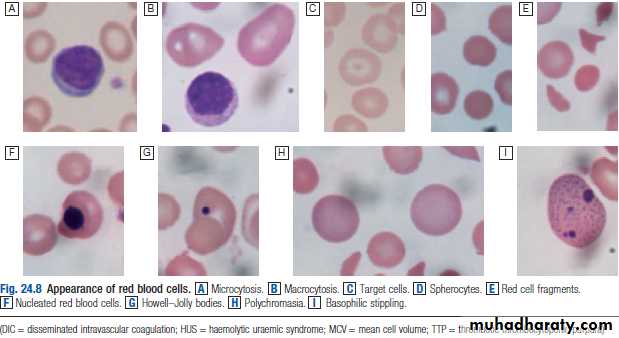

LEC.4 Dr.Khaled
MEDICINEHEMOLYTIC DESORDERS
Red Cell Turnover and Life Span 2.5 million red cells are removed from the circulation every second. BM produces 200 billion new red cells (reticulocytes) each day. These cell survived for 120 days before they are removed by the RES ( BM, liver, spleen).
CLASSIFICATION1.Acute versus chronic .2.Acquired versus congenital. 3.Intra-vascular versus extra-vascular. 4.Intra-corpuscular versus extra-corpuscular
HEMOLYTIC ANAEMIA
Definition HA is a decrease in the total number of circulating erythrocytes that is caused by the premature destruction or removal of red cells from the circulation. Anaemia will result only if the rate of RBCdestruction exceed the BM response (un compensation).
Clinical features
Chronic congenital HA Acute (Acquired) HA
Anaemia sudden pallorJaundice JaundiceCrisis TachycardiaSplenomegaly Aching pain,Gall stones headache,Leg ulcers malaise Skeletal abnormalities , vomiting
, shaking chills and fever
Manifestation of the underlying disease.
Laboratory manifestation
I. signs of excessive RBC destruction:Decrease RBC life span Increase catabolism of heme.indirect hyperbilirubinaemia
increase rate of bilirubin production.
increase rate of urobilinogen production
increase LDH activity .
Absence of serum haptoglobin
Signs of intra-vascular hemolysis
Hemoglobinaenemia.
Hemoglobinuria. Haemosiderinuria. Met-heme-albuminaemia.
Decrease hemopexin
Decrease Hb level.
II. signs of accelerated erythropoiesis
Blood
Reticulocytosis (polychromasia in the blood film).
Macrosytosis
Normoblastaemia .
Leukocytosis and thrombocytosis..
Bone marrow. Erythroid hyperplasia. Ferrokinetics: increase plasma iron turnover . increase erythrocyte iron turnover
Differential diagnosis. Thein DD III.Lab tests useful
Morphology(blood film findings) :
(spherocytes, elliptocytes, acanthocytes, stomatocytes, target cells, fragmented RBCs, Autoagglutination) Direct coomb’s test (Direct anti-human globulin-DAT) Osmotic fragility test Auto-hemolysis test Hb-electorphoresis test
Screening test for G6PD deficiency
Sickling test
DIRECT ANTIHUMAN GLOBULIN (DAT)
Testing the patient RBC for their invivo sensitization. It is used in ;1.Transfusion reaction,
2. Hemolytic disease of the newborn.
3. Auto immune hemolytic anaemia(AIHA)
4.Drug-induced hemolytic anaemia.
INDIRECT ANTI-HUMAN GLOULIN TEST (IAT)
Testing the patient serum for the presence of irregular antibodies (Allo);
1.Part of cross matching.
2.Antibody screening & identification.
3.Titration of antibodies.
Direct antiglobulin test Indirect antiglobulin test
Differential Diagnosis Of Hemolytic Anaemia
1.Anaemia with increase Reticulocytes:a. Haemorrage
b.Recovery from deficiency of iron, B12, folate.
c. Recovery from marrow failure as in cessation of alcohol cosumption.
2.Anaemia with acholuric jaundice;
a.Ineffective erythropoiesis.
b. Loss of blood in to body cavity.
3.Acholuric jaundice without anaemia.
4.Marrow invasion.
5.myoglobulinuria.